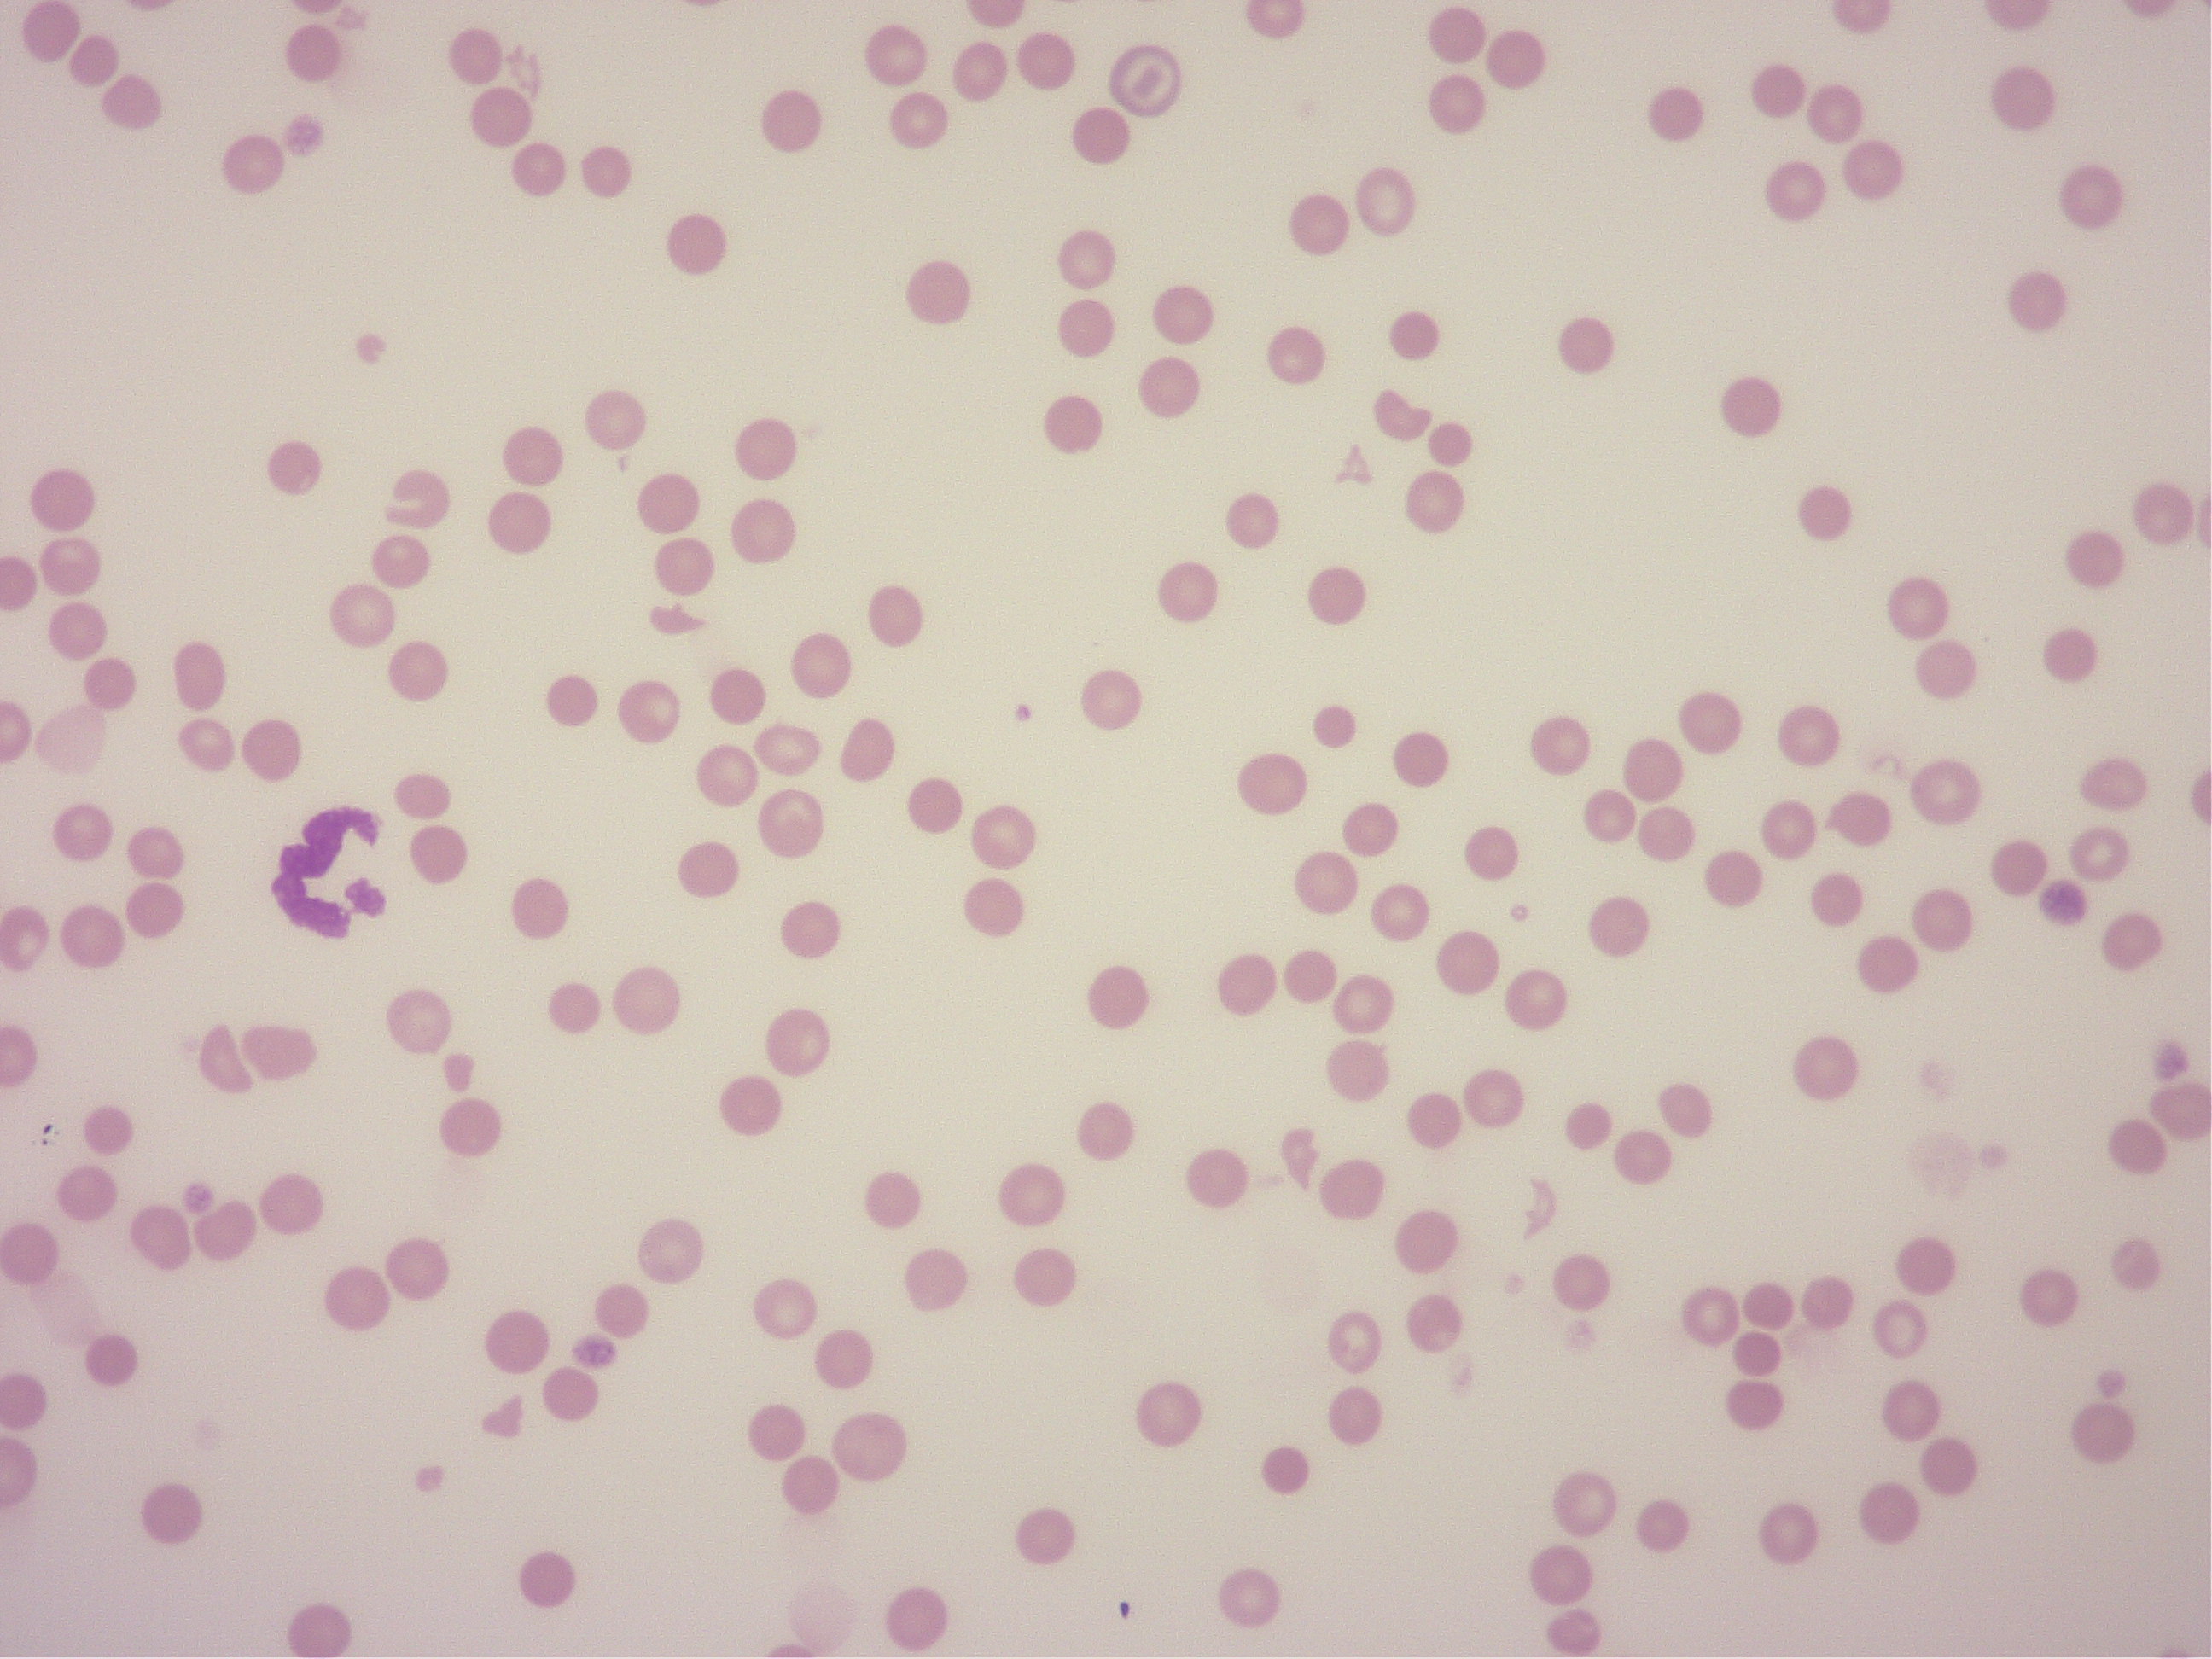
破砕赤血球の血液塗沫検査

みなさん、こんにちは。院長の諏訪です。
激しい雨と雷が多い日が続きますね。
雨が降ってないと思ったら、すごく暑かったりもします。
雷で体調崩したり、暑さで熱中症になったりと、
注意することがたくさんです。
おかしいなと思ったら、早めのご来院をお勧めいたします。
上の写真はガチャガチャで見つけた
「猫砂スノードーム」です。
猫砂を撒き散らしている姿が見ていて楽しいです。
よくできています。
第2駐車場完成のお知らせ
当院から30mほど、隣の隣の隣に第2駐車場ができました!
反対側車線からUターンせずに入れます。
余裕を持って作っていただいたので当院前より停めやすいです。
まだ看板ができていないので、わかりにくいかと思いますが、
当院ご利用の方は遠慮なく停めてください!

がん学会参加報告
7月1日、2日は休診とさせていただきました。
ご迷惑おかけいたしました。
東京で行われた日本獣医がん学会に参加してきました。
今回のメインテーマは「膵臓腫瘍」でした。
膵臓腫瘍は大きく膵内分泌腫瘍と膵外分泌腫瘍に分けられます。
よく遭遇するのは、膵内分泌腫瘍の一つである
インスリノーマですが、それ以外にもガストリノーマや
グルカゴノーマなどがあります。
どれも診断が難しい腫瘍になりますが、
それぞれに特徴的な所見もあります。
普段あまり遭遇しないからこそ、
学会の場で勉強し直し、知識をアップデートすることは
非常に大切なことだと思います。
今回は人医学の先生のお話も聞けて、大変勉強になりました。
また、個人的には司会の仕事もさせていただきました。

日進月歩の獣医療です。
日々、勉強して少しでも皆様のお役に立てるよう精進いたします。
がんと血液
なかなかご紹介できそうな論文がなかったので、
今回は「がん」と「血液」という内容でお話しさせていただこうと思います。
僕は「腫瘍学」と「血液学」に力を入れて学んできました。
「腫瘍学」に関しては、日本獣医がん学会の認定医の資格もとりました。
「血液学」に関しては、血液学の巨匠である恩師から
多くのことを学ばせていただきました。
まだまだどちらの学問も勉強している最中であり、
現状に満足せず、日々の努力を怠らないように常に心がけています。
もちろん、それ以外の分野に関しても
動物臨床医学会の総合臨床認定医の資格をとり、
どの学問も満遍なく精通していきたいと思っています。
資格をもっているということが、偉いとか、すごいとかではなく、
自分が生涯勉強していくということを宣言しているようなものだと
自分に言い聞かせています。
実は昨日で当院は開院して4年が経過しました。
ありがたいことに、腫瘍や血液疾患を疑う症例のご紹介も増えてきました。
そんな中で「貧血」や「血小板減少症」を発見されて
当院へ紹介来院し、検査をした結果、「腫瘍」がみつかる症例は
少なくありません。
「貧血」や「血小板減少症」の原因が腫瘍疾患であることは
比較的多いのです。
症例紹介
例えば、「貧血」と「血小板減少症」で紹介来院した猫です。
いろいろな検査をしましたが、原因がわからないとのことでした。
この子は骨髄検査を実施したところ、骨髄の中にがん細胞がたくさん
認められた症例です。

この子の「貧血」や「血小板減少症」の原因は
「リンパ腫」というがんで、骨髄ろうの状態になったために、
貧血などが起こったと考えられます。
別の症例です。
三系統減少症で紹介来院した犬です。
この症例は当院で検査を行ったところ、脾臓に腫瘍が見つかりました。
脾臓摘出時に行った骨髄検査では正常な骨髄像でした。

この子は脾臓の腫瘍により、貧血や血小板減少症が引き起こされていた
と考えられます。
このように、がんと血液はよく結び付きます。
もちろん、がんと関係のない血液疾患も多く見られます。
こういったことから、血液疾患が疑われても腫瘍性疾患が疑われても、
多くの検査とコストが必要となってきます。
最後の症例です。
「貧血」に対して免疫抑制治療をしているものの、
治らないとのことで紹介来院した犬です。
この子は血液塗抹を顕微鏡で観察したところ、
多くの赤血球がちぎれた所見を認めました。
これは破砕赤血球とよばれる赤血球で、
血栓症などの存在が疑われます。
とくにがんによるDICを発症した場合にはよく観察されます。
この子はその後の検査で肝臓に腫瘍がみつかりました。
まとめ
本日は、血液と腫瘍の関係についてお話ししました。
すべてにあてはまるわけではありませんが、
なんとなくでも参考になると幸いです。
当院は開院、5年目になります。
一日一日を大切にし、
日々精進して参ります。
これからも何卒よろしくお願いいたします。
